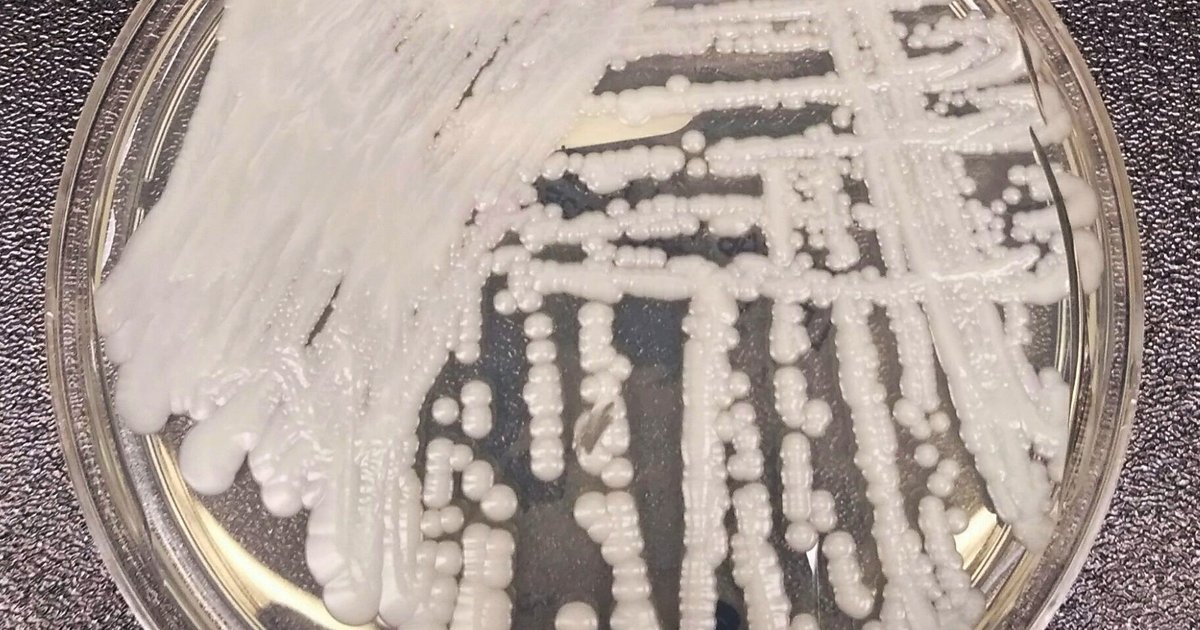
Philly health department warns of increasing cases of C. auris, a drug-resistant fungal infection

More aggressive measures are needed to combat the rise of drug-resistant fungal infections in health care facilities, public health officials say.
An advisory issued earlier this month by the Philadelphia Department of Public Health alerted health care providers to a “significant increase” in infections caused by Candida auris, a yeast that is resistant to multiple medications. C. auris can cause skin infections and life-threatening bloodstream infections, the Centers for Disease Control and Prevention says.
MORE: Medical marijuana reclassified by Trump administration as a less dangerous drug
Because C. auris spreads easily in health care facilities and has become resistant to several anti-fungal drugs, it is a growing threat nationwide. There has been a steep increase in infections since the COVID-19 pandemic. Research from Michigan State University – to be presented at a worldwide conference on infectious diseases this fall – has characterized C. auris infections as a global health challenge, calling its spread in the United States “alarming.”
C. auris cases have climbed each year since it the fungal infections were first detected in the United States in 2016. The first C. auris cases in Philadelphia were detected in 2020, and have increased each year since then, with more than 500 total cases reported. Of those, 221 were reported in 2025, up from 103 reported cases in 2024, the health department said.
Symptoms of infection may include fever and chills. But people can have C. auris on their skin or bodies – or be “colonized” – without being infected.
People who are colonized do not need treatment, but they can spread the infection onto surfaces around them and to other patients, said Dr. Jane Gould, the medical director for the health department’s Healthcare-Associated Infections/Antimicrobial Resistance Program.
Outbreaks can occur in health care settings, including hospitals and ventilator skilled nursing facilities, Gould said in an email.
People using feeding tubes, ventilators or central venous catheters are at higher risk of a C. auris infection, the advisory said.
Why are cases rising?
Increased screening, including admissions testing at several health care facilities in Philadelphia, is part of the reason why more cases are being reported, Gould said.
“The increase in infections in sick patients is most likely a result of more C. auris in Philadelphia facilities overall, resulting from spread within healthcare facilities and increased numbers of colonized patients,” Gould said.
Longer lengths of stays in acute care facilities can lead to infections. But “spread has been shown even with exposure as short as 4 hours to a contaminated healthcare environment,” Gould said.
People taking broad-spectrum antibiotics or antifungal medications, who have had recent surgery or who have diabetes are at heightened risk for getting C. auris. Most infections have been in adults, with a small number of pediatric cases reported nationwide, Gould said.
For most C. auris cases, treatment options are still available, she said.
How to prevent the spread
Proper cleaning and disinfecting in health care settings and hand hygiene helps prevent the spread of C. auris.
Suspected or confirmed cases of C. auris should be reported to the health department at (215) 685-6748, according to the advisory, which contains more detailed information about preventing the spread.